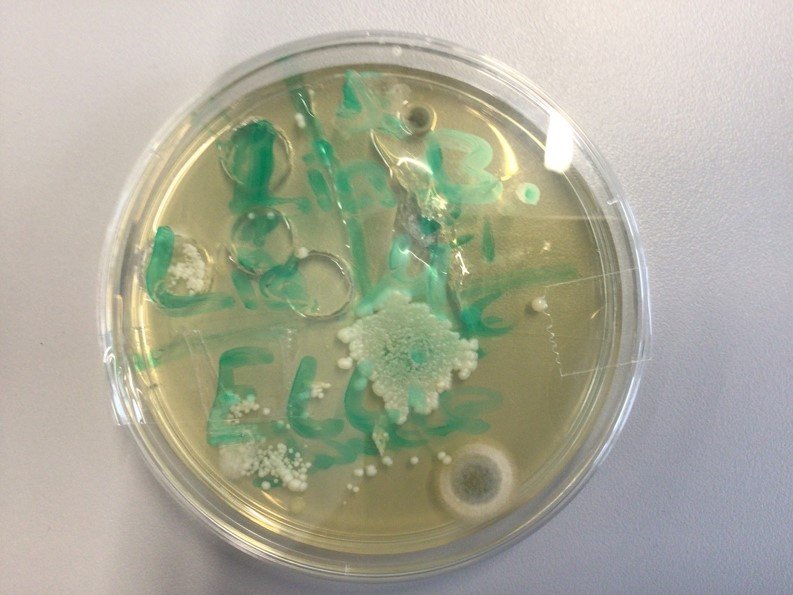
Abklatschversuch

Die Biologie erforscht das Leben
Biologie gehört mit Physik und Chemie zu den Naturwissenschaften. Naturwissenschaftler erforschen die gesamte Umwelt des Menschen. Sie stellen Fragen zur Natur und versuchen diese Fragen mithilfe von Beobachtungen und Experimenten zu beantworten.
In der Realschule wird das Fach Biologie in den Jahrgangsstufen 5, 6, 7, 8 und 10 mit jeweils zwei Wochenstunden unterrichtet.
Schwerpunkte in den einzelnen Jahrgangsstufen.
Jahrgangsstufe 5:
- Der Körper des Menschen und seine Gesundheit
- Körperbau und Lebensweise von Säugetieren
- Vielfalt und Besonderheiten bei Blütenpflanzen
Jahrgangsstufe 6:
- Stammesgeschichtliche Entwicklung der Wirbeltiere
- Lebewesen bestehen aus Zellen
- Stoffwechsel bei Pflanzen
- Lebensgemeinschaft Wald/Wiese
Jahrgangsstufe 7:
- Kommunikation und Informationsverarbeitung
- Programme und Regeln für das Zusammenleben
- Menschliche Sexualität und Entwicklung
- Sucht/Drogen
Jahrgangsstufe 8:
- Mikroorganismen und Viren
- Schutz- und Abwehrsystem des Menschen
- Lebensgemeinschaft Gewässer
Jahrgangsstufe 10:
- Genetik
- Regeln der Vererbung – Angewandte Genetik
- Verantwortliche Elternschaft
- Biologische und kulturelle Evolution des Menschen
Arbeitsweisen im Biologieunterricht
- Betrachten, beobachten und vergleichen (z. B. Vögel im Winter, Lebewesen im Schulgarten, Bäume im Park)
- Kenn- und Bestimmungsübungen (z. B. Anlegen eines Herbars, was blüht in unserem Schulgarten)
- Untersuchen (z. B. Bau einer Vogelfeder)
- Arbeiten mit Lupe und Mikroskop (z. B. Tiere im Teich, Querschnitt durch ein Laubblatt)
- Experimentieren (z. B. Funktion der Schwimmblase, Lotuseffekt)
- Herstellen von und arbeiten an Modellen (z. B. Zellmodell, Chromosomenmodell)
- Präsentieren (z. B. kleine Präsentationen über ein selbst gewähltes Tier in der 5. und 6. Klasse)
Exkursionen und Projekte
- Zusätzliche MINT-Stunde in den Fächern Biologie, Physik und Chemie ( 5. Jahrgangsstufe)
- Besuch des Tierheims (5. Jahrgangsstufe)
- Exkursion in den Wald (6. Jahrgangsstufe)
- Exkursion in den Botanischen Garten (6. Jahrgangsstufe)
- Besuch des „Dunkelcafes“ (7. Jahrgangsstufe)
- „Hundeschule“ zum Thema Kommunikation und Lernen (7. Jahrgangsstufe)
- Sexualpädagogischer Workshop in Zusammenarbeit mit dem SkF (8. Jahrgangsstufe)
- Besuch der Schwangerenberatungstelle des SkF, fächerübergreifend mit der Fachschaft Religion (10. Jahrgangsstufe)
- Betreuung des Schulaquariums
- Aktion „Saubere Schule“
- Gestaltung eines "Grünen Klassenzimmers" in Kooperation mit der Firma Brose
Aktuelles - Kreative Praxis im Biologieunterricht
Zellmodelle aus Knete
Im Biologieunterricht der 7. Jahrgangsstufe drehte sich in den letzten Wochen alles um das Thema Zellen. Doch statt nur trockener Theorie wurde es nun kreativ: Die Schülerinnen hatten die Aufgabe, Zellmodelle aus Knete zu gestalten! Mit bunten Farben und viel Fantasie entstanden detailreiche Modelle von tierischen und pflanzlichen Zellen. Ob Zellkern, Mitochondrien oder Zellwand – alles wurde präzise nachgebildet. Dabei bewiesen unsere jungen Biologen nicht nur ihr Wissen, sondern auch handwerkliches Geschick. Mit viel Spaß lernten sie, wie die Bausteine des Lebens aufgebaut sind. Am Ende konnten alle stolz ihre Knetwerke präsentieren.
Auf Spurensuche nach Mikroorganismen - Abklatschversuche
Im Biologieunterricht der 8. Jahrgangsstufe ging es kürzlich auf spannende Spurensuche: Mit sogenannten Abklatschversuchen untersuchten die Schülerinnen, wo sich auf Alltagsgegenständen Mikroorganismen verstecken. Ob Türklinken, Handys oder Beauty-Artikel – mit speziellen Nährböden nahmen sie Proben von verschiedenen Oberflächen.Nach einigen Tagen in warmer Umgebung, zeigte sich das faszinierende Ergebnis: winzige, oft unsichtbare Mikroorganismen hatten sich zu Kolonien entwickelt, die nun auf den Nährböden sichtbar waren. Die Schülerinnen staunten nicht schlecht, als sie die Vielfalt an Bakterien und Pilzen auf den Proben entdeckten. So wurde allen eindrucksvoll bewusst, wie wichtig Hygiene im Alltag ist. Das Experiment brachte den Aha-Effekt – und den ein oder anderen dazu, sein Handy mal gründlich zu reinigen!
L. Esteban